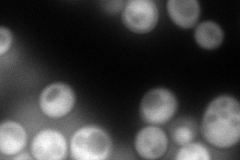
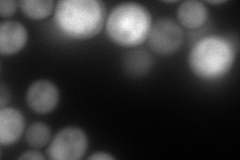
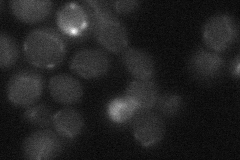
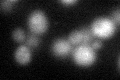

View description
Maltase (alpha-D-glucosidase), inducible protein involved in maltose catabolism; encoded in the MAL1 complex locus
Localization:
Intensity:
Fold change:
Significance:
-
C’ GFP library in SD

cytosol18.77 -
N' NOP1pr-GFP in SD
cytosol216.568 -
N' TEF2pr-mCherry in SD
nucleus214.891 -
N' NATIVEpr-GFP in SD
below threshold20.0058 -
N' TEF2pr-VC and Cyto-VN in SD

#N/A0 -
C’ GFP library in SD+DTT
cytosol19.521.03No -
C’ GFP library in SD+H2O2

cytosol18.760.99No -
C’ GFP library in Starvation Media

cytosol16.490.87No -
C’ GFP library on the background of Pup2-DaMP

cytosol -
C’ GFP library on the background of CCT mutant

cytosol20.19371.07528No
